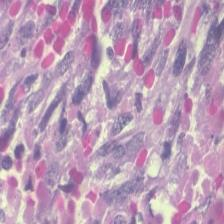
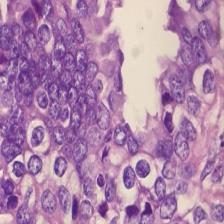
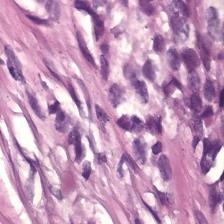
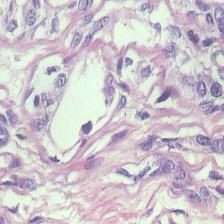
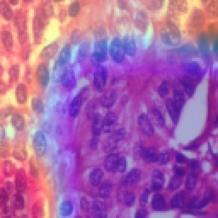
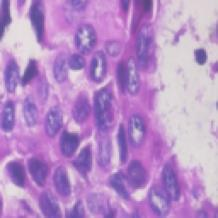

We present a novel technique to discover and exploit weak causal signals directly from images via neural networks for classification purposes. This way, we model how the presence of a feature in one part of the image affects the appearance of another feature in a different part of the image. Our method consists of a convolutional neural network backbone and a causality-factors extractor module, which computes weights to enhance each feature map according to its causal influence in the scene. We developed different architecture variants and empirically evaluated all of our models on two public datasets of prostate MRI images and breast histopathology slides for cancer diagnosis. To confirm our quantitative results, we conduct ablation studies and investigate the explainability of our models via class activation maps. Our findings show that our lightweight block extracts meaningful information and improves the overall classification, together with producing more robust predictions that focus on relevant parts of the image. That is crucial in medical imaging, where accurate and reliable classifications are essential for effective diagnosis and treatment planning.
翻译:暂无翻译